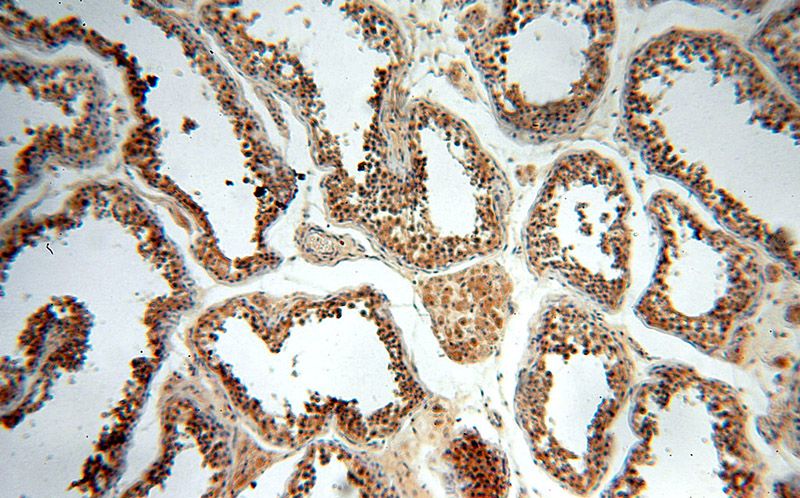
Immunohistochemical of paraffin-embedded human testis using Catalog No:110684(FKBPL antibody) at dilution of 1:50 (under 10x lens)
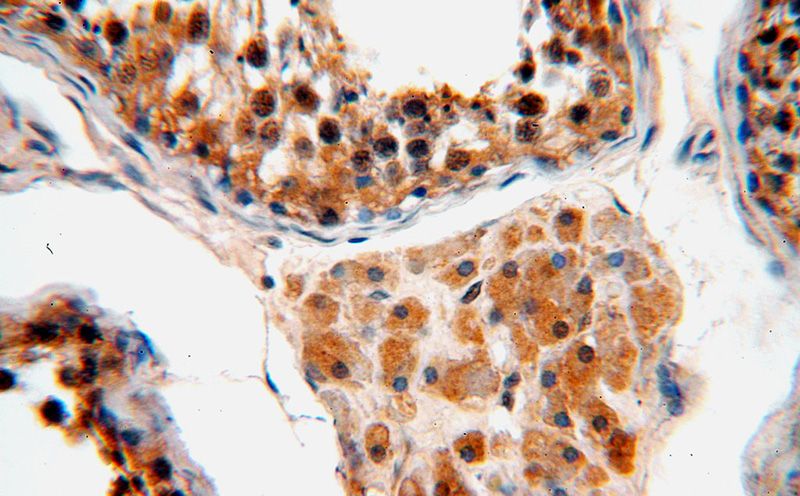
Immunohistochemical of paraffin-embedded human testis using Catalog No:110684(FKBPL antibody) at dilution of 1:50 (under 40x lens)

-
Product Name
FKBPL antibody
- Documents
-
Description
FKBPL Rabbit Polyclonal antibody. Positive IHC detected in human testis tissue, human breast cancer tissue. Positive IP detected in MCF-7 cells. Positive WB detected in MCF7 cells, COLO 320 cells, HEK-293 cells, HeLa cells, human brain tissue, human testis tissue, Jurkat cells, MDA-MB-453s cells. Observed molecular weight by Western-blot: 42-48 kDa; 38-40 kDa
-
Tested applications
ELISA, WB, IHC, IP
-
Species reactivity
Human,Mouse,Rat; other species not tested.
-
Alternative names
DIR1 antibody; FK506 binding protein like antibody; FKBPL antibody; NG7 antibody; WISP39 antibody
-
Isotype
Rabbit IgG
-
Preparation
This antibody was obtained by immunization of FKBPL recombinant protein (Accession Number: NM_022110). Purification method: Antigen affinity purified.
-
Clonality
Polyclonal
-
Formulation
PBS with 0.1% sodium azide and 50% glycerol pH 7.3.
-
Storage instructions
Store at -20℃. DO NOT ALIQUOT
-
Applications
Recommended Dilution:
WB: 1:200-1:2000
IP: 1:200-1:2000
IHC: 1:20-1:200
-
Validations

MCF7 cells were subjected to SDS PAGE followed by western blot with Catalog No:110684(FKBPL antibody) at dilution of 1:500

IP Result of anti-FKBPL (IP:Catalog No:110684, 3ug; Detection:Catalog No:110684 1:800) with MCF-7 cells lysate 2500ug.
Immunohistochemical of paraffin-embedded human testis using Catalog No:110684(FKBPL antibody) at dilution of 1:50 (under 10x lens)
Immunohistochemical of paraffin-embedded human testis using Catalog No:110684(FKBPL antibody) at dilution of 1:50 (under 40x lens)
-
Background
FKBPL, also named as DIR1, NG7 and WISp39, has similarity to the immunophilin protein family, which plays a role in immunoregulation and basic cellular processes involving protein folding and trafficking. FKBPL levels may be a prognostic indicator and determinant of response to endocrine therapy(PMID:20103631, 15664193) .It can be detected the band between 38 Kda and 48 Kda by western blot.
-
References
- Yakkundi A, McCallum L, O'Kane A. The anti-migratory effects of FKBPL and its peptide derivative, AD-01: regulation of CD44 and the cytoskeletal pathway. PloS one. 8(2):e55075. 2013.
- Bennett R, Yakkundi A, McKeen HD. RALA-mediated delivery of FKBPL nucleic acid therapeutics. Nanomedicine (London, England). 2015.
- Yakkundi A, Bennett R, Hernández-Negrete I. FKBPL is a critical antiangiogenic regulator of developmental and pathological angiogenesis. Arteriosclerosis, thrombosis, and vascular biology. 35(4):845-54. 2015.
- Nelson L, McKeen HD, Marshall A. FKBPL: a marker of good prognosis in breast cancer. Oncotarget. 6(14):12209-23. 2015.
- Donley C, McClelland K, McKeen HD. Identification of RBCK1 as a novel regulator of FKBPL: implications for tumor growth and response to tamoxifen. Oncogene. 33(26):3441-50. 2014.
- McKeen HD, McAlpine K, Valentine A. A novel FK506-like binding protein interacts with the glucocorticoid receptor and regulates steroid receptor signaling. Endocrinology. 149(11):5724-34. 2008.
- Bublik DR, Scolz M, Triolo G, Monte M, Schneider C. Human GTSE-1 regulates p21(CIP1/WAF1) stability conferring resistance to paclitaxel treatment. The Journal of biological chemistry. 285(8):5274-81. 2010.
- McKeen HD, Byrne C, Jithesh PV. FKBPL regulates estrogen receptor signaling and determines response to endocrine therapy. Cancer research. 70(3):1090-100. 2010.
Related Products / Services
Please note: All products are "FOR RESEARCH USE ONLY AND ARE NOT INTENDED FOR DIAGNOSTIC OR THERAPEUTIC USE"
